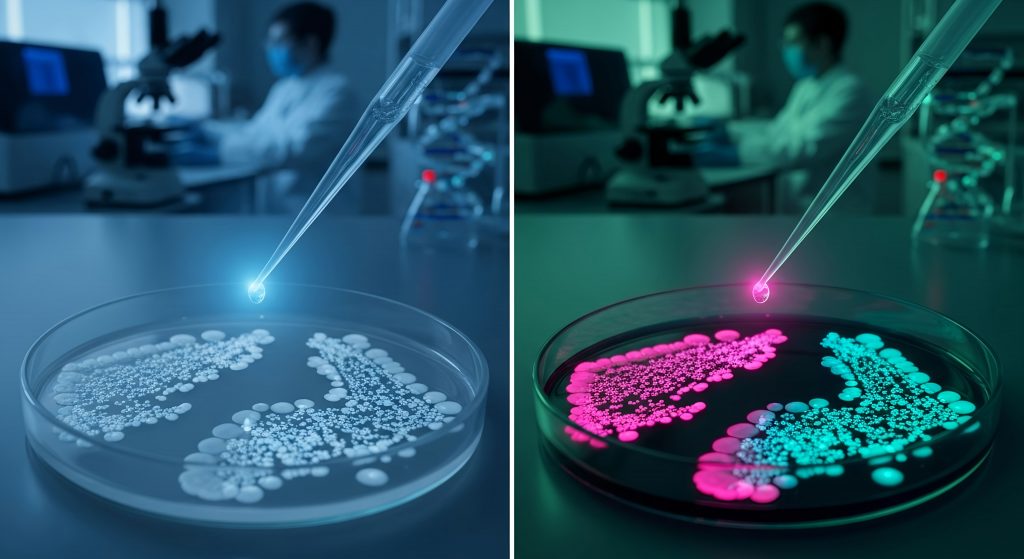

Bifidobacteria Biofilm Formation in Probiotic Products | Gut Health Study
Probiotics are widely used to support gut health, but not all strains are equally effective once they enter the digestive system. A crucial feature that determines a probiotic’s performance is its ability to form biofilms – structured communities of bacteria encased in a protective matrix. Biofilm formation allows probiotics to resist stomach acid, attach to the intestinal lining, and maintain a lasting presence in the gut microbiome.
This research investigates the biofilm formation capability of Bifidobacteria strains commonly found in commercial probiotic yogurts and dietary supplements.
Objectives
This project aimed to:
- Assess the biofilm-forming ability of Bifidobacteria strains isolated from consumer probiotic products
- Determine the genetic diversity of these strains using ITS-PCR molecular typing
- Explore the relationship between biofilm strength and incubation time
Methodology
A total of eight Bifidobacteria isolates were obtained from different probiotic yogurts and supplements. These were tested using a combination of microbiological assays and molecular techniques.
Tools and Techniques Used
- Biofilm Assay: Biofilm formation was evaluated at 24, 48, and 72-hour intervals using microtiter plate assays. Optical density readings were used to quantify biofilm strength.
- ITS-PCR Molecular Typing: The ITS region between the 16S and 23S rRNA genes was amplified using the Bt-2 primer set. Gel electrophoresis was used to visualize DNA banding patterns and assess strain diversity.
- Statistical Analysis: One-way ANOVA followed by post-hoc tests was conducted using SPSS to analyze the relationship between incubation time and biofilm strength.
Key Findings
- Biofilm Strength Improved Over Time: Most isolates showed increased biofilm formation between 24 and 72 hours. The strongest activity was generally observed at 48 hours, indicating that prolonged incubation enhances colonization potential.
- Genetically Diverse Strains Identified: PCR results revealed distinct DNA patterns for each isolate, confirming they were not duplicate strains. This genetic diversity increases the likelihood of functional variability and resilience in the gut.
- Correlation Between Biofilm and Survival: Statistical results showed a significant correlation between incubation time and biofilm density (p < 0.05). This suggests that biofilm maturity may be a predictive marker for probiotic viability in real-world digestive environments.
Clinical and Consumer Significance
The ability of probiotics to form biofilms is not just a laboratory metric; it has real-world health implications. Strains with strong biofilm-forming ability are more likely to:
- Survive stomach acid and bile
- Persist in the gut longer
- Outcompete harmful bacteria
- Deliver more consistent digestive and immune benefits over time
For consumers, this means that not all probiotic supplements or yogurts are equal. Some may contain strains that are scientifically proven to colonize the gut effectively, while others may lose viability before they reach the intestine.
For clinicians and product formulators, these findings support the need for evidence-based strain selection grounded in both microbiological and genetic analysis.
Conclusion
This study provides concrete evidence that commercial probiotic products can contain biofilm-forming, genetically distinct Bifidobacteria strains capable of surviving digestive challenges and supporting gut health. The strong correlation between incubation time and biofilm development highlights the importance of selecting robust strains for therapeutic and consumer use.
Future research may explore whether these traits translate into improved clinical outcomes, such as reduced gastrointestinal symptoms or enhanced immune function.
